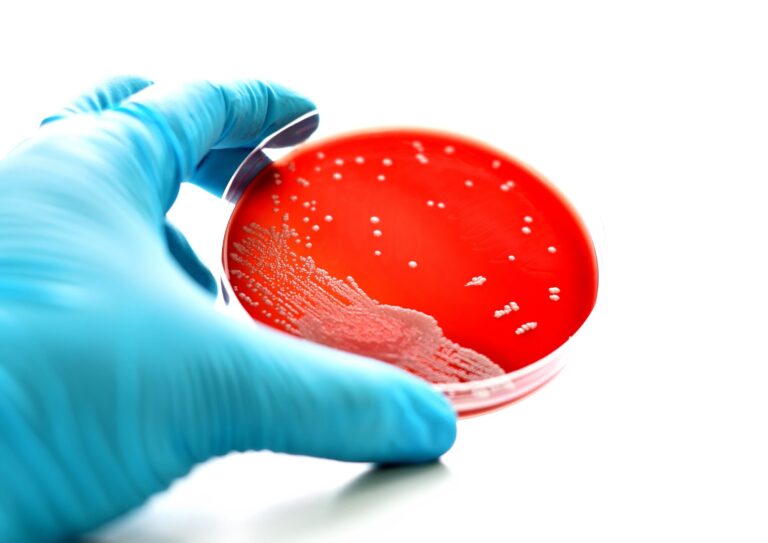

-
HPVワクチン・検査・陽性フォロー完全ガイド|シルガード9接種対応【医師監修】
-
トリコモナス(腟トリコモナス)— 症状・うつる経路・検査/費用・治療のすべて
-
ウレアプラズマ感染症(検査・治療)|恵比寿駅徒歩3分で当日対応。常在菌と症状を解説
-
マイコプラズマの症状(排尿痛・おりもの異常・無症状)や検査、治療(耐性菌対応)
-
【医師監修】尖圭コンジローマは薬で治る?痛くない治療と写真解説|モイストクリニック恵比寿
-

HIVとは?症状・感染経路・検査・治療をわかりやすく解説
-

ヘルペス(口唇・性器)の症状と治療|恵比寿モイストクリニック
-
梅毒とは?症状・感染経路・検査・治療をわかりやすく解説
-
淋菌(淋病)とは? ― 症状・感染経路・検査・治療を専門医が解説
-
クラミジア(性器・のど)検査・治療|恵比寿のモイストクリニック



